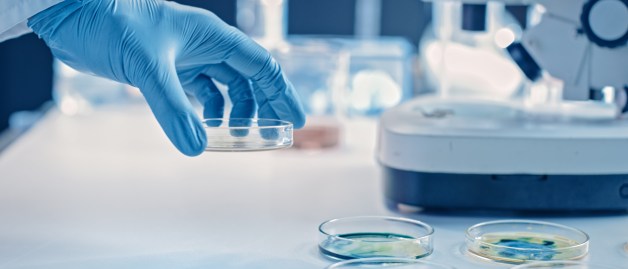

Infektionskrankheiten – bakterielle und virale Infektionen nachhaltig bekämpfen
Infektionskrankheiten wie AIDS (HIV) oder Pneumokokken-Infektionen sind eine stete Gefahr für unsere Gesundheit. MSD forscht daher an Vorsorge- und Behandlungsmöglichkeiten gegen Krankheiten, die durch Viren, Bakterien oder andere Erreger verursacht werden – um Menschenleben weltweit zu retten.
Wir durchbrechen Infektionsketten
In unserer globalisierten Welt besteht die Gefahr, dass sich neue Erreger schnell ausbreiten, auch solche, gegen die es weder Therapiemöglichkeiten noch Impfstoffe gibt. Die schnelle Ausbreitung der SARS-CoV-2-Infektion innerhalb weniger Wochen ist ein dramatisches Beispiel. Seit mehr als 100 Jahren engagieren wir uns deshalb im Kampf gegen virale und bakterielle Infektionskrankheiten. Heute sind wir eines der führenden Unternehmen in der Entwicklung von Medikamenten und der Erforschung neuer Wirkstoffe.
Wir entwickeln …
- effektive Arzneimittel wie Antibiotika, um zum Beispiel schwere bakterielle Infektionen wirksam zu behandeln,
- wirkungsvolle Impfstoffe, um Krankheiten vorbeugend und langfristig zu besiegen.

Globale Verantwortung
Wir setzen uns dafür ein, dass unsere innovativen Medikamente weltweit, bezahlbar und fair verteilt werden. Seit 1987 engagieren wir uns zum Beispiel mit einem Spendenprogramm gegen Flussblindheit und Elefantiasis. MSD hat sich verpflichtet, das Medikament Mectizan so lange kostenfrei zur Verfügung zu stellen, bis die Flussblindheit weltweit eliminiert ist. Jährlich können wir so mehr als 300 Menschen helfen. Seit Beginn des Programms haben wir mehr als 4,4 Milliarden Behandlungseinheiten an Menschen in 49 Ländern gespendet.

Geballtes Wissen
Um den Fortschritt Fortschritte zu beschleunigen, kooperieren wir mit Fachleuten aus Wissenschaft und Gesundheitswesen sowie anderen Pharmaunternehmen aus der ganzen Welt. Mit vereintem Know-how treiben wir den medizinischen Fortschritt bei schweren Infektionen voran. Gegen das Zaire-Ebola-Virus beispielsweise haben wir den ersten verfügbaren Impfstoff entwickelt und uns an der Forschung und Produktion von Arzneimitteln und Impfstoffen gegen COVID-19 beteiligt.
Herausforderungen im Bereich Infektionskrankheiten
Antibiotika sind die Standardtherapie bei der Behandlung schwerer bakterieller Infektionen. Langfristig können allerdings resistente Keime entstehen, bei welchen Standard-Antibiotika wirkungslos sind (z. B. Multi-resistenter Staphylococcus aureus (MRSA), Multi-resistente gram-negative (MRGN) Bakterien). So könnten wir eine wirksame Waffe im Kampf gegen Infektionskrankheiten verlieren.
Aus diesem Grund treiben wir als eines von wenigen Pharmaunternehmen weltweit die Entwicklung neuer Reserveantibiotika voran – damit uns im Kampf gegen bekannte und neue Erreger weiterhin wirkungsvolle Therapien zur Verfügung stehen.

Wir waren eines der ersten Unternehmen, das sich im Kampf gegen HIV engagierte. Seit fast 40 Jahren helfen wir, Menschen mit HIV ein längeres, gesünderes und selbstbestimmtes Leben zu ermöglichen. Wir setzen uns außerdem für Aufklärung und gegen Stigmatisierung von Menschen mit HIV ein und unterstützen unter anderem das Programm #positivarbeiten der Deutschen Aidshilfe gegen Diskriminierung von Menschen mit HIV im Arbeitsleben.
Unsere Erfolge
haben wir begonnen Penicillin “G“ zu produzieren – unser erstes Antibiotikum
Jahre beteiligen wir uns intensiv an der HIV-Forschung.
Programme gegen Antibiotikaresistenzen unterstützen wir weltweit.